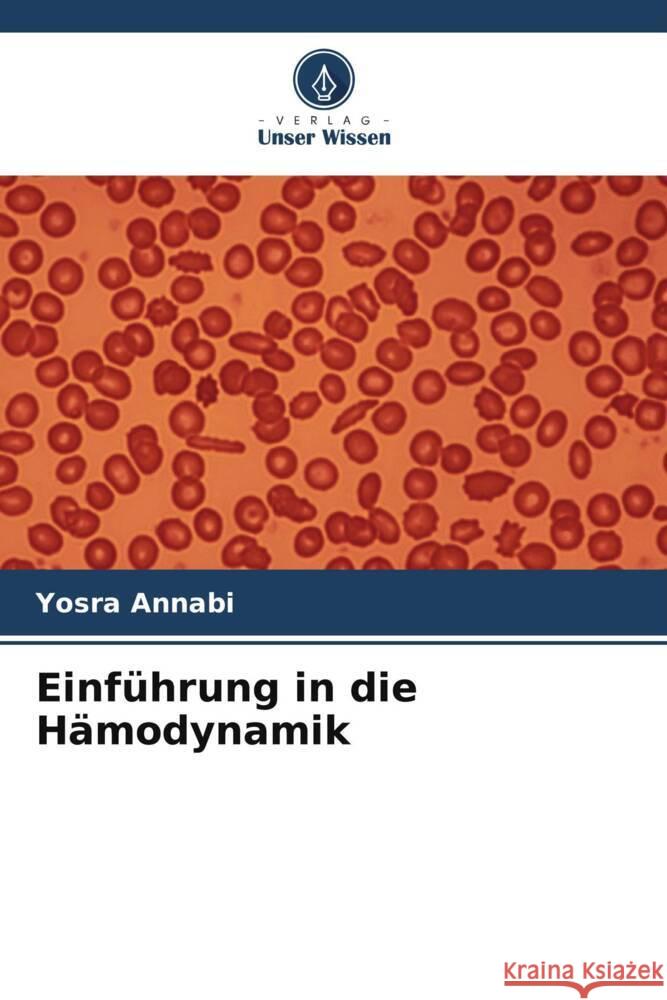
Einführung in die Hämodynamik Annabi, Yosra 9786205148396 Verlag Unser Wissen - książka

Einführung in die Hämodynamik » książka
Einführung in die Hämodynamik
ISBN-13: 9786205148396 / Miękka / 72 str.
Dieses Buch stellt eine Literaturarbeit über die Modellierung der Blutdynamik dar. Es beschreibt im ersten Kapitel die Anatomie des Herz-Kreislauf-Systems und die Funktionsweise des Blutkreislaufs. Das zweite Kapitel ist der Flüssigkeit gewidmet. Es beschreibt die biophysikalischen Eigenschaften des Blutes, seine Zusammensetzung und die Eigenschaften der Elemente, aus denen es besteht. In den letzten beiden Kapiteln werden die Strömungsmechanismen untersucht. So erklärt das dritte Kapitel die Fließmechanismen von Partikeln im Plasma. Einige Mechanismen sind passiv, wie Diffusion und Osmose. Andere werden als erzwungen oder aktiv bezeichnet, wie z. B. der erzwungene Transport, da er elektrochemische Energie benötigt, um zu geschehen. Das letzte Kapitel befasst sich mit den Arten des Blutflusses und den Energiequellen, die einen kontinuierlichen Blutfluss ermöglichen. Normalerweise ist der Blutfluss laminar, es sei denn, es liegt eine Krankheit vor. Im Anhang finden Sie Fotos von Blutgefäßen tierischen Ursprungs sowie Fotos von sezierten Herzen tierischen Ursprungs.